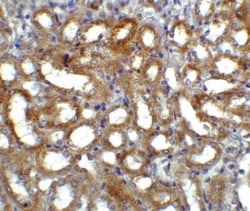
GFR alpha-3/GDNF R alpha-3 Antibody, Novus Biologicals:Antibodies:Primary

missing translation for 'onlineSavingsMsg'
Learn More
Learn More
GFR alpha-3/GDNF R alpha-3 Antibody, Novus Biologicals™
Rabbit Polyclonal Antibody
£141.00
Specifications
| Antigen | GFR alpha-3/GDNF R alpha-3 |
|---|---|
| Concentration | 1 mg/mL |
| Dilution | Western Blot 0.5 μg/mL, ELISA 1:100-1:2000, Immunohistochemistry 5 μg/mL, Immunocytochemistry/Immunofluorescence 5 μg/mL, Immunohistochemistry-Paraffin 5 μg/mL |
| Applications | Western Blot, ELISA, Immunohistochemistry, Immunocytochemistry, Immunofluorescence, Immunohistochemistry (Paraffin) |
| Classification | Polyclonal |
Description
GFR alpha-3/GDNF R alpha-3 Polyclonal specifically detects GFR alpha-3/GDNF R alpha-3 in Human, Mouse, Rat samples. It is validated for Western Blot, ELISA, Immunohistochemistry, Immunocytochemistry/Immunofluorescence, Immunohistochemistry-Paraffin.Specifications
| GFR alpha-3/GDNF R alpha-3 | |
| Western Blot 0.5 μg/mL, ELISA 1:100-1:2000, Immunohistochemistry 5 μg/mL, Immunocytochemistry/Immunofluorescence 5 μg/mL, Immunohistochemistry-Paraffin 5 μg/mL | |
| Polyclonal | |
| Rabbit | |
| Cytokine Research, Immunology | |
| PBS with 0.02% Sodium Azide | |
| GDNF family receptor alpha 3, GDNF family receptor alpha-3, GDNF receptor alpha-3, GDNFR-alpha-3, GFRa-3, GFR-alpha-3, glial cell line-derived neurotrophic factor receptor alpha-3, GPI-linked receptor | |
| GFRA3 | |
| IgG | |
| Ion exchange chromatography | |
| 43 kDa |
| 1 mg/mL | |
| Western Blot, ELISA, Immunohistochemistry, Immunocytochemistry, Immunofluorescence, Immunohistochemistry (Paraffin) | |
| Unconjugated | |
| RUO | |
| Human, Mouse, Rat | |
| O35118 | |
| 2676 | |
| Antibody was raised against a 14 amino acid peptide near the center of murine GFR alpha 3. The immunogen is located within the last 50 amino acids of GFR alpha 3. Amino Acid Squence: RFHSQLFSQDWPHPT | |
| Primary | |
| Store at 4°C short term. Aliquot and store at -20°C long term. Avoid freeze-thaw cycles. |
For Research Use Only
Spot an opportunity for improvement?Share a Content Correction
Product Content Correction
Your input is important to us. Please complete this form to provide feedback related to the content on this product.
Product Title